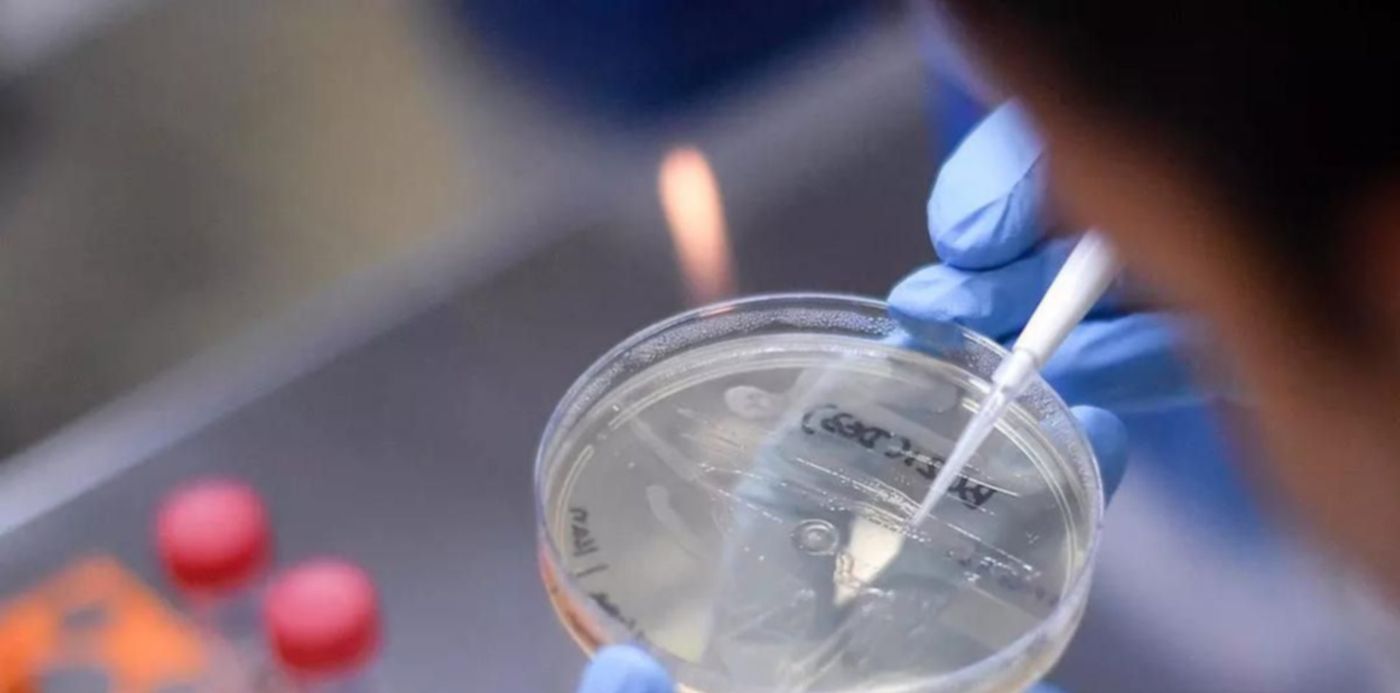
1624303272186.jpg?&cw=1920&ch=950

Un grupo de científicos del Reino Unido advirtió que las consecuencias en las infecciones con esta variación pueden ser alarmantes y hablan del riesgo de desarrollar un Covid a largo plazo. Así lo afimó el británico Danny Altmann, profesor de inmunología en el Imperial College, en base a la evidencia de varios países que sugiere que una cantidad significativa de personas que contraen el virus corren el riesgo de desarrollar la enfermedad durante un período prolongado.
Conocida como “Long Covid” o “Covid persistente”, y reportada en algunos primeros casos a mitad del año pasado, quienes se ven más afectados son en su mayoría jóvenes que padecen problemas de salud derivados de su positivo por varios meses. Los síntomas son fatiga, dificultad para respirar, dolores en el pecho, dificultades para dormir y problemas de memoria y concentración (denominados “niebla mental”).
"Es una pesadilla para cualquiera planificar con precisión porque es algo muy resbaladizo de controlar. No entendemos hacia dónde nos dirigimos porque estamos en un territorio realmente inexplorado, pero sabemos lo suficiente para comprender que parece bastante serio y bastante aterrador”, indicó el profesor. Las causas por las que algunos pacientes padecen Covid con síntomas por meses aún no están claras.
La comunidad científica se inclina por varias opciones; hay quienes creen que se trata de una serie de afecciones diferentes con una combinación de causas, otros entienden que lo más probable es que el virus persista por esa cantidad de tiempo en el cuerpo y forme pequeños reservorios, que son los que complican la salud por meses. Y para muchos estas infecciones prolongadas se deben al impacto que tiene el virus en las defensas inmunitarias.

Mientras tanto el director general de la Organización Mundial de la Salud (OMS), Tedros Adhanom Ghebreyesus, denunció que la pronunciada desigualdad en el acceso a las vacunas responde a “egoísmo” y exhortó a las farmacéuticas a entregar dosis a los países pobres en vez de tratar de convencer a los ricos a que compren más.
En este marco, también se mostró en alerta por la variante Delta. Tras 10 semanas en que disminuyeron las muertes por coronavirus a nivel mundial, la tasa de mortandad está nuevamente aumentando y esta variante está “provocando olas catastróficas de casos del virus”, declaró Ghebreyesus. El pedido de la organización tuvo lugar ayer, día en que la OMS constató la presencia de la variante Delta, más contagiosa, en “más de 140 países”, según declaró Maria Van Kerkhove, responsable de emergencias sanitarias de la organización.